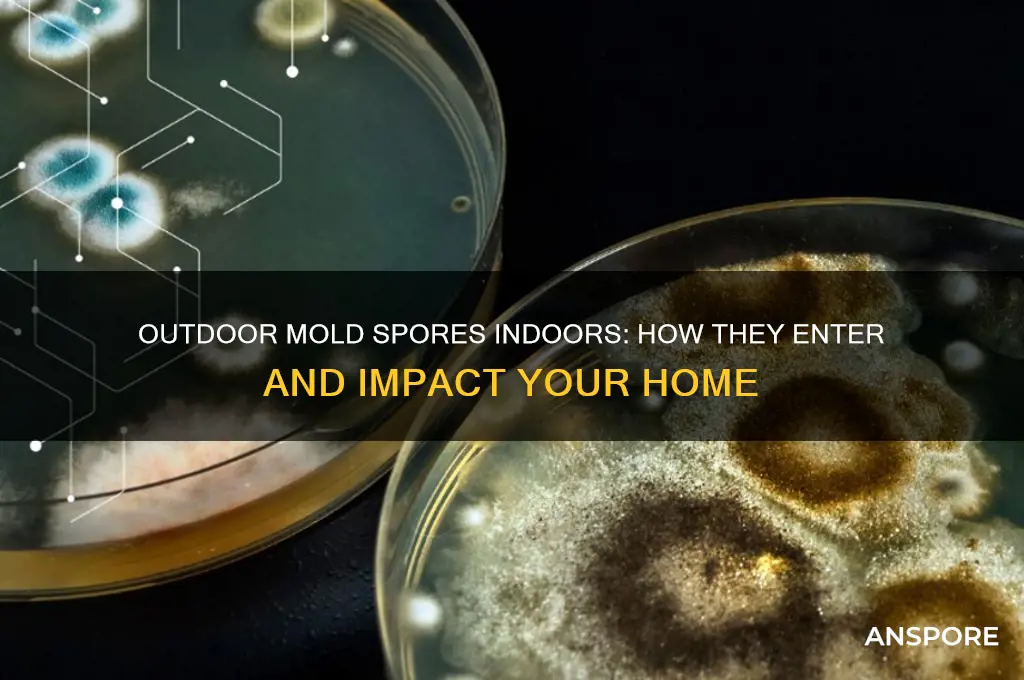
do outdoor mold spores come in your house

Outdoor mold spores are microscopic particles that naturally exist in the environment, thriving in soil, plants, and decaying organic matter. While they play a crucial role in ecosystems, these spores can easily become airborne and travel indoors through open windows, doors, HVAC systems, or even on clothing and pets. Once inside, they may settle on surfaces or multiply in damp areas, potentially leading to indoor mold growth if conditions are favorable. Understanding how outdoor mold spores enter your home is essential for preventing mold-related issues and maintaining a healthy indoor environment.
| Characteristics | Values |
|---|---|
| Can outdoor mold spores enter the house? | Yes, outdoor mold spores can easily enter the house through open doors, windows, vents, and even on clothing, shoes, and pets. |
| Common entry points | Openings like doors, windows, HVAC systems, cracks in walls, and foundations. |
| Factors increasing indoor entry | High outdoor mold spore counts, windy conditions, proximity to mold sources (e.g., compost piles, wooded areas), and poor indoor ventilation. |
| Survival indoors | Outdoor mold spores can survive indoors if conditions are favorable (e.g., moisture, organic material, and warmth). |
| Health risks | Can trigger allergies, asthma, and respiratory issues, especially in sensitive individuals. |
| Prevention methods | Keep doors and windows closed during high spore counts, use air purifiers with HEPA filters, maintain indoor humidity below 60%, and regularly clean HVAC systems. |
| Seasonal variation | Outdoor mold spores are more prevalent in warm, humid seasons like spring, summer, and fall. |
| Detection methods | Air quality tests, visible mold growth, or musty odors may indicate indoor mold presence. |
| Remediation | Improve ventilation, fix leaks, clean affected areas with mold-killing solutions, and consider professional mold remediation if necessary. |
Explore related products
$13.48 $14.13
$32.98 $34.99
What You'll Learn

Sources of Outdoor Mold Spores
Outdoor mold spores are ubiquitous, floating in the air and settling on surfaces both outside and, inevitably, inside your home. These microscopic particles originate from various natural sources, making it nearly impossible to eliminate them entirely. Understanding where they come from is the first step in managing their presence indoors.
Natural Reservoirs: The Great Outdoors
Mold spores thrive in damp, organic environments, and nature provides plenty of these. Decaying leaves, rotting wood, soil, and even plants themselves are prime breeding grounds. For instance, a single cubic meter of outdoor air can contain anywhere from 100 to 1,000 mold spores, depending on the season and location. After rain or in humid climates, these numbers spike dramatically. Even your garden or nearby forests contribute to the spore count, especially during fall when leaves decompose rapidly.
Entry Points: How Spores Sneak In
Spores don’t need an invitation to enter your home. They hitch a ride on air currents, attaching themselves to clothing, shoes, and pets. Open windows, doors, and vents are obvious gateways, but spores also infiltrate through HVAC systems, cracks in walls, and even on fresh produce brought indoors. A study found that homes with open windows for just 15 minutes a day had 30% more outdoor spores than those kept sealed. Even if you live in a dry climate, wind-blown dust from distant areas can carry spores into your space.
Seasonal Shifts: Timing Matters
The concentration of outdoor mold spores fluctuates with the seasons. Spring and summer bring higher humidity and warmer temperatures, ideal for mold growth. For example, Basidiospores, common in late summer, can travel miles on air currents, while Alternaria spores peak in late summer and fall. Tracking local spore counts (available through weather apps or allergy forecasts) can help you prepare. Closing windows during high-spore periods and using air purifiers with HEPA filters can reduce indoor infiltration by up to 50%.
Practical Prevention: Simple Steps, Big Impact
While you can’t stop spores from entering your home entirely, you can minimize their impact. Start by maintaining indoor humidity below 50%—mold thrives above this level. Regularly clean or replace air filters, and vacuum with a HEPA-filtered machine to trap spores. Wipe down pets after outdoor play and remove shoes at the door to avoid tracking in spores. For those with allergies or asthma, consider using a dehumidifier in damp areas like basements or bathrooms. Small changes, like these, can significantly reduce the presence of outdoor mold spores indoors.
Do Morel Spore Kits Work? Unveiling the Truth for Mushroom Growers
You may want to see also

Entry Points for Mold Spores
Outdoor mold spores are ubiquitous, floating in the air and settling on surfaces with every breeze. While they’re a natural part of the environment, their infiltration into homes can lead to indoor mold growth, triggering allergies, respiratory issues, and structural damage. Understanding how these spores enter your home is the first step in preventing their unwelcome presence.
Cracks and Gaps: The Unseen Invitations
Mold spores are microscopic, measuring between 3 to 40 microns in size, making them small enough to slip through the tiniest openings. Common entry points include gaps around windows, doors, and foundation cracks. A 1/16-inch gap is sufficient for spores to infiltrate, especially during windy conditions. Inspect your home annually for such vulnerabilities, sealing them with caulk or weatherstripping. For larger gaps, consider expanding foam insulation, which acts as both a barrier and an insulator.
Ventilation Systems: A Double-Edged Sword
While proper ventilation is essential for reducing indoor humidity, it can also inadvertently invite mold spores. HVAC systems, exhaust fans, and even open windows can pull outdoor air—and its spore cargo—indoors. To mitigate this, install high-efficiency particulate air (HEPA) filters in your HVAC system, capable of trapping particles as small as 0.3 microns. Regularly clean or replace filters every 1-3 months, depending on usage and manufacturer guidelines. For natural ventilation, use window screens with fine mesh to block spores while allowing airflow.
Foot Traffic and Pets: Unintentional Carriers
Humans and pets are mobile spore carriers, tracking mold from outdoor environments into the home. Shoes alone can carry thousands of spores per square inch, especially after walking through damp areas like gardens or wooded trails. Implement a "no-shoe" policy indoors, and provide a designated area for footwear near the entrance. For pets, wipe their paws with a damp cloth after outdoor activities. Washing pet bedding weekly in hot water (140°F or higher) can also eliminate spores that cling to fur.
Moisture Intrusion: The Catalyst for Spores
Once inside, mold spores require moisture to germinate and grow. Water leaks, high humidity, and condensation create ideal conditions for their proliferation. Monitor indoor humidity levels with a hygrometer, keeping them below 50%. Address leaks promptly, especially in hidden areas like under sinks or behind walls. In humid climates, consider using dehumidifiers in basements, bathrooms, and other prone areas. Regularly inspect gutters and downspouts to ensure water is directed away from the foundation, reducing the risk of moisture seepage.
By identifying and addressing these entry points, you can significantly reduce the likelihood of outdoor mold spores taking root in your home. Proactive measures not only protect your health but also preserve the integrity of your living space, ensuring a safer and more comfortable environment for all occupants.
Exploring Spore's Multiplayer Mode: Cooperative Gameplay and Online Features
You may want to see also

Impact on Indoor Air Quality
Outdoor mold spores are ubiquitous, and their infiltration into indoor spaces is inevitable. These microscopic particles, carried by air currents, can easily pass through open windows, doors, and even HVAC systems. Once inside, they settle on surfaces, multiply under favorable conditions, and degrade indoor air quality (IAQ). The impact of outdoor mold spores on IAQ is twofold: they contribute to the overall spore count and, when combined with indoor moisture, can foster mold growth, releasing mycotoxins and volatile organic compounds (VOCs) that exacerbate respiratory issues.
Consider the mechanics of spore entry. A typical home exchanges indoor and outdoor air several times a day, particularly in regions with high wind speeds or during activities like airing out rooms. For instance, a study found that outdoor mold spore concentrations can spike during fall seasons due to leaf decomposition, leading to a 30-50% increase in indoor spore counts if windows are left open. This influx is particularly problematic for individuals with allergies, asthma, or compromised immune systems, as even low-level exposure can trigger symptoms like sneezing, coughing, or skin irritation.
To mitigate this, homeowners can adopt proactive measures. Using high-efficiency particulate air (HEPA) filters in HVAC systems can capture up to 99.97% of particles as small as 0.3 microns, effectively reducing spore infiltration. Additionally, monitoring indoor humidity levels—ideally keeping them below 50%—prevents spores from germinating into mold colonies. For those in high-risk areas, such as near forests or compost sites, installing window screens with fine mesh can act as a physical barrier without compromising ventilation.
Comparatively, the impact of outdoor spores on IAQ differs from that of indoor mold. While outdoor spores are generally diverse and transient, indoor mold colonies produce higher concentrations of allergens and toxins in confined spaces. For example, *Cladosporium* and *Aspergillus*, common outdoor molds, may enter homes but rarely cause significant issues unless they find damp environments to thrive. In contrast, indoor molds like *Stachybotrys* (black mold) release potent mycotoxins that can lead to severe health complications, even in small doses.
In conclusion, outdoor mold spores are an inescapable component of indoor air, but their impact on IAQ can be managed through informed strategies. By understanding spore behavior, employing filtration systems, and controlling moisture, homeowners can minimize their presence and prevent secondary mold growth. For vulnerable populations, such as children under 5 or adults over 65, these steps are not just precautionary—they are essential for maintaining a healthy living environment. Regular IAQ testing, especially during seasonal transitions, can provide actionable insights to further safeguard indoor spaces.
Transforming into an Epic Creature in Spore: Possibility or Myth?
You may want to see also
Explore related products
$15.2 $20.64

Preventing Mold Spore Infiltration
Outdoor mold spores are ubiquitous, floating through the air and settling on surfaces both outside and, inevitably, inside your home. While it’s impossible to eliminate them entirely, strategic measures can significantly reduce their infiltration and prevent mold growth. The key lies in controlling entry points and maintaining an environment hostile to spore proliferation.
Sealing the Perimeter: A First Line of Defense
Mold spores enter homes through gaps in windows, doors, vents, and even cracks in foundations. Inspect your home’s exterior for vulnerabilities, particularly around window frames, door thresholds, and attic vents. Use weatherstripping, caulk, or expanding foam to seal these openings. For larger gaps, consider hiring a professional to ensure airtight closure. Properly installed door sweeps and window seals can reduce spore entry by up to 70%, according to the EPA. Additionally, ensure dryer vents and exhaust fans are vented outdoors and free of obstructions to prevent moisture buildup, a spore magnet.
Ventilation and Humidity Control: Starving Spores of Their Lifeline
Mold spores thrive in damp, stagnant environments. Maintaining indoor humidity below 50% is critical. Use dehumidifiers in basements, bathrooms, and other high-moisture areas, ensuring they’re emptied regularly. Run exhaust fans during showers and cooking to expel humid air. In climates with high outdoor humidity, consider a whole-house dehumidifier. Regularly clean or replace HVAC filters to prevent spore circulation through the system. For optimal results, set dehumidifiers to maintain 45–50% humidity, as levels above 60% create ideal conditions for mold growth.
Landscaping and Outdoor Maintenance: A Proactive Approach
Outdoor mold sources, such as decaying leaves, mulch, or damp woodpiles, can release spores that hitch a ride indoors on shoes, pets, or air currents. Keep gutters clean to prevent water from pooling near foundations, and slope landscaping away from the house to discourage moisture accumulation. Trim vegetation at least 12 inches from exterior walls to improve airflow and reduce spore concentration near entry points. Avoid using organic mulch directly against the house; opt for gravel or rubber alternatives instead.
Air Quality Solutions: Filtering Out the Invisible
While sealing and ventilation are primary defenses, air purifiers with HEPA filters can capture airborne spores, particularly in high-risk areas like bedrooms or living spaces. Look for models with a CADR (Clean Air Delivery Rate) of at least 300 for pollen and dust, as these are effective against spores. For whole-house protection, consider installing a HEPA filtration system in your HVAC unit. However, filters alone cannot prevent mold growth if moisture issues persist, so address the root cause first.
By combining these strategies—sealing entry points, controlling humidity, managing outdoor sources, and enhancing air quality—you create a multi-layered defense against mold spore infiltration. While spores are unavoidable, their impact on your home’s health doesn’t have to be.
Spore Bacteria Shapes: Filament or Rod? Unraveling the Mystery
You may want to see also

Health Risks of Indoor Mold Growth
Outdoor mold spores are everywhere, and they can easily find their way into your home through open doors, windows, vents, and even on your clothing or pets. While these spores are a natural part of the environment, their presence indoors can lead to mold growth under the right conditions—moisture, warmth, and organic material. Once mold takes hold, it becomes more than just an eyesore; it poses significant health risks, particularly for vulnerable populations.
Consider the case of *Stachybotrys chartarum*, commonly known as black mold. This toxic mold produces mycotoxins that, when inhaled or touched, can cause severe respiratory issues, skin irritation, and even neurological symptoms. Infants, the elderly, and individuals with compromised immune systems or pre-existing respiratory conditions like asthma are especially at risk. For example, prolonged exposure to mold spores can exacerbate asthma symptoms, leading to increased frequency and severity of attacks. Studies show that children living in mold-infested homes are 30–50% more likely to develop asthma, highlighting the critical need to address indoor mold growth promptly.
Preventing mold-related health risks begins with controlling indoor moisture levels. Fix leaks immediately, ensure proper ventilation in bathrooms and kitchens, and maintain indoor humidity below 60%. If mold is already present, small areas (less than 10 square feet) can often be cleaned with a solution of water and detergent. However, larger infestations require professional remediation to avoid spreading spores. Wearing protective gear, such as gloves and masks, is essential during cleanup to minimize exposure.
Comparing the health impacts of mold to other indoor pollutants, mold stands out for its ability to cause both immediate and long-term health issues. Unlike dust or pollen, mold releases spores and mycotoxins that can accumulate in the body over time, leading to chronic conditions. For instance, prolonged exposure to mold has been linked to hypersensitivity pneumonitis, a rare but serious condition causing inflammation in the lungs. This underscores the importance of treating mold growth as a serious health hazard, not just a cosmetic issue.
In conclusion, while outdoor mold spores are inevitable, their transformation into indoor mold growth is preventable. By understanding the health risks—from respiratory problems to chronic illnesses—and taking proactive steps to control moisture and address mold promptly, you can protect your household from its harmful effects. Remember, early detection and action are key to maintaining a healthy indoor environment.
Effective Strategies to Eliminate Mold Spores and Prevent Growth
You may want to see also
Frequently asked questions
Yes, outdoor mold spores can easily enter your house through open doors, windows, vents, and even on clothing, shoes, or pets.
Outdoor mold spores are generally harmless in small quantities, but they can grow indoors if conditions are damp, leading to potential health issues like allergies or respiratory problems.
Use air filters, keep windows and doors closed during high-spore seasons, remove shoes at the door, and regularly clean or vacuum to minimize indoor spore accumulation.
Outdoor mold spores can cause indoor mold growth if they land on damp surfaces and find suitable conditions, such as high humidity or water damage.
Yes, air purifiers with HEPA filters can effectively capture and reduce the number of outdoor mold spores circulating indoors, improving air quality.

























